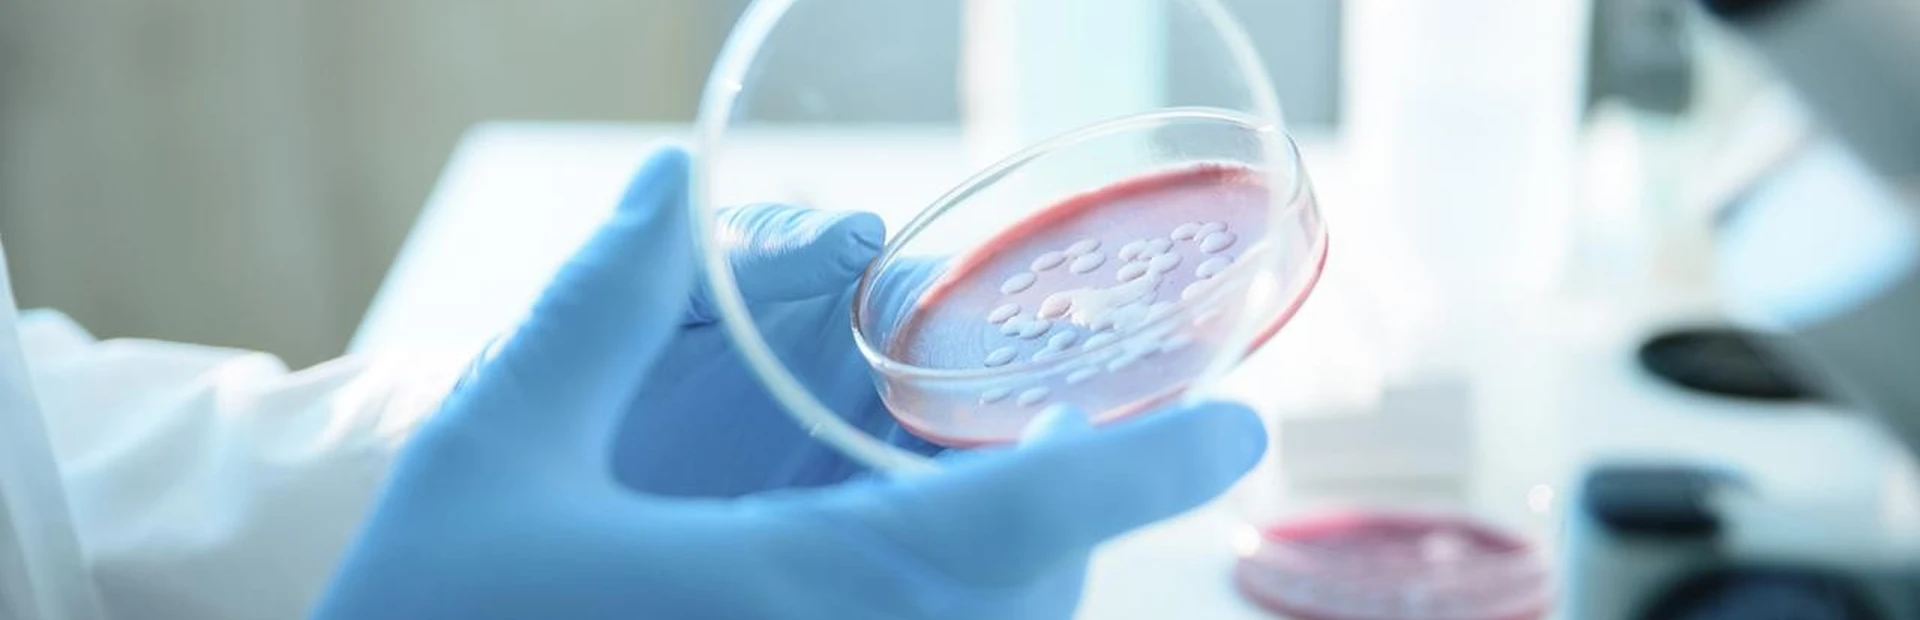

When Donald Ganem, MD, joined the NIBR team as head of the Infectious Disease (ID) group in January 2011, he made what he calls a natural step in a career always focused at the intersection of research and clinical medicine.
“Those who know me very well could have predicted that I would make this move to come to NIBR,” says Ganem who had been on faculty at the University of California, San Francisco (UCSF) for the past 30 years in both the departments of infectious disease and medicine. He had also been a member of NIBR's Scientific Advisory Board for the past six years.
Ganem has been active in the laboratory in some sort since his college days at Harvard. Indeed, he was the last undergraduate to work in the bacterial genetics laboratory of what was then the (James) Watson/(Walter) Gilbert lab.

Ganem brings with him a lauded career in microbiology and virology, particularly the search for novel viruses responsible for devastating human disease. But his love of microbiology started in his days in high school. His childhood heroes were the 19th century microbiologists like Koch, Pasteur, and Erlich, who discovered new diseases and pathogens and how they caused disease. Even his reading reflected his passion. “A whole generation of kids my age read a book called The Microbe Hunters and were hooked,” recalls Ganem. He knew he would pursue a career that would always unite his clinical interests with scientific research.
Ganem earned his medical degree at Harvard, all the while maintaining an active research focus. He had discovered a passion for molecular biology and chose to work on SV40 DNA replication. “It was then that I fell in love with virology,” he says. Once he completed his MD degree, Ganem chose to pursue a subspecialty fellowship in the virology laboratory of UCSF's Harold Varmus.
Once at UCSF, Ganem began what turned out to be a 30-year run of virology discoveries always maintaining his appointment as a practicing physician. At the height of the AIDS crisis in San Francisco and elsewhere, his laboratory was at the center of discovering the viral etiological cause of Kaposi's sarcoma (KS), a cancer that became one of the hallmark manifestations of HIV/AIDS. Ganem and colleagues determined that KS was in fact caused by a novel virus, human herpesvirus 8.
“We were the first group to grow the virus in tissue culture and built one of the first blood tests for infection that we used on almost 5,000 patients,” Ganem says. He recalls this moment in the mid '90s as the first time in his career when he proceeded from a molecular biology project through virus cultivation, serologic test building, to clinical investigation. “I had a blast doing that. It was so exciting,” says Ganem. “I felt I was doing what I had trained all my life to do - science and medicine.”
So, when the opportunity came to join NIBR as ID disease area head, it deeply resonated with Ganem in part because he knew the organization and had a feel for the high caliber of the people and the genre of the work. He was deeply impressed that NIBR scientists were living fully in that familiar space between science and medicine. “I knew that if I were ever going to really have a fundamental hand in treatment - not just in administering treatment but in developing it - then this was the moment in time to embrace it.” He laughingly, but tellingly, points out that he is now old enough to know how to do the job well and still young enough to do it effectively.
With roots in the Bay Area, Ganem joins NIBR at the Emeryville site where ID will be headquartered going forward. “Emeryville is an ideal site to grow the ID portfolio,” he says. The site has the room and the area draws on the rich intellectual talents of the Bay Area. It is not lost on Ganem that the Emeryville site grew from the Novartis acquisition of Chiron, the biotech company that developed the first HCV diagnostic test in the late '80s and was home to a strong hepatitis program. Ganem intends to make HCV a large focus of NIBR's ID program going forward.
The leadership at NIBR continues to draw people with clinical backgrounds, including Ganem. “You have to be cognizant of the clinical issues when you design and manage a program like this,” he says. In his first two weeks on the job, Ganem reviewed the ID portfolio to reorient it towards his perception of where the outstanding clinical needs will be in the next 10-15 years.
Ganem is drawn to NIBR as the model organization within big pharma where risk taking in a judicious way is not only allowed but also encouraged. “Being willing to take risks is a necessary precondition to innovation. I find it appealing that NIBR does not recoil from risk,” he says. “It will be my job to shape what projects are risk worthy and important enough to pursue.”